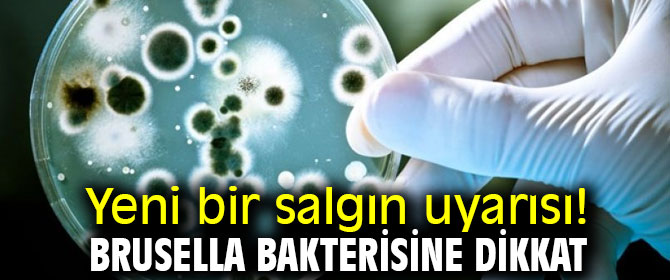

Yeni bir salgın uyarısı! Brusella bakterisine dikkat
Bir ilaç firmasının tesislerinden yayılan “brusella” bakterisinin 3 bini aşkın kişiye bulaştığı belirtiliyor.
Corona virüs salgınının ardından Çin'de şimdi de yeni bir salgın başgösterdi. Olay Çin'in Lanzhou kentinde meydana geldi. Brusella bakterisine karşı aşı üreten ilaç firmasının ihmalkarlığı salgına yol açtı.
Kentin sağlık yetkililerine göre, aşı üretimi sırasında, buhar emisyonlarının yanlış ve hatalı sterilizasyonu bakterinin yayılmasına yol açtı. Bakterinin koyun, sığır ve domuzlar aracılığıyla 3 bin 245 kişiye bulaştığı belirtiliyor. Yetkililer, hastalara ekim ayından itibaren tazminat ödeyeceklerini duyurdu. Brusella hastalığı baş ve kas ağrısı, ateş, yorgunluk gibi semptomlara neden olabiliyor.










Türkçe karakter kullanılmayan ve büyük harflerle yazılmış yorumlar onaylanmamaktadır.